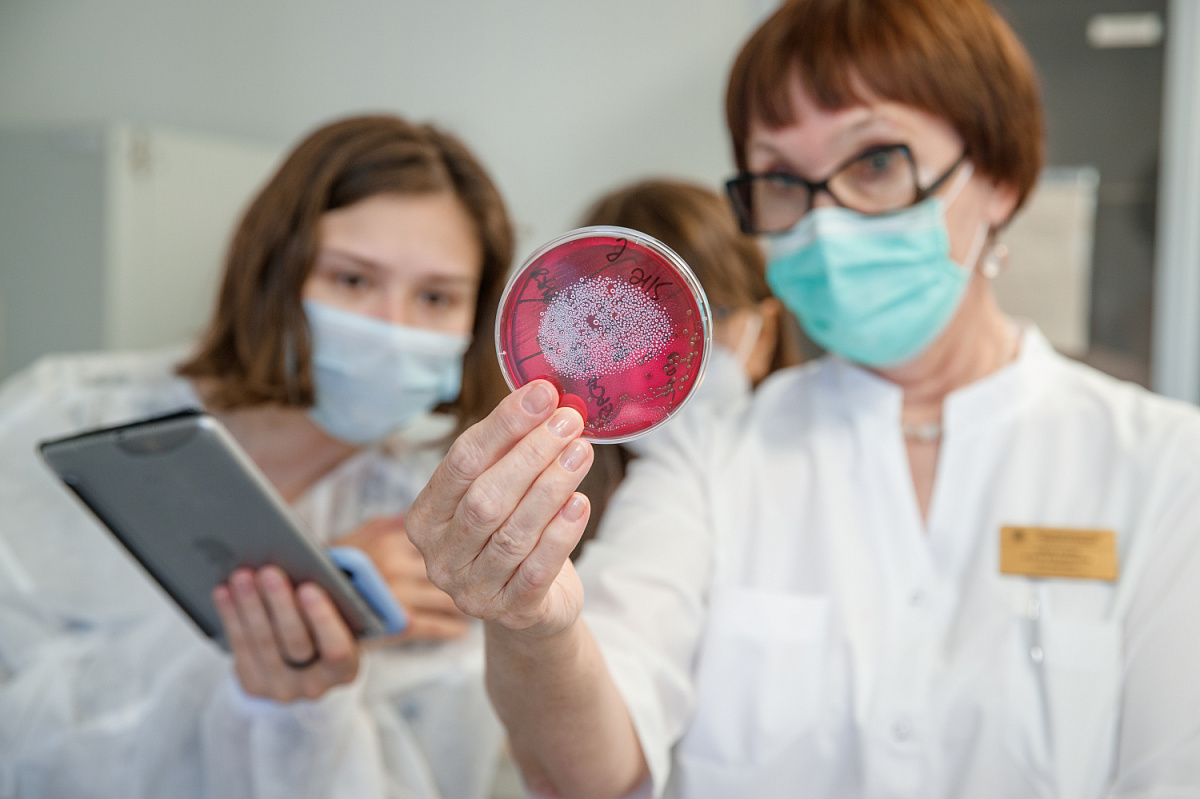
РКИБ: главный рубеж в борьбе с инфекциями

От небольшого учреждения до ведущего медцентра
История больницы началась в конце XIX века, когда Казань страдала от эпидемий. Горожане сталкивались с высокой смертностью от таких болезней, как тиф, холера, оспа и скарлатина. Тогда Городская дума приняла решение создать специальное медицинское учреждение для борьбы с инфекциями.
В 1899 году на окраине Казани была открыта первая больница на 40 коек. Вскоре после революции 1917 года во время эпидемий тифа и холеры она стала ключевой в борьбе с инфекциями.

Здание 2-ой инфекционной больницы. Фото: сайт РКИБ
В 1929 году началось строительство новых корпусов под руководством педиатра и инфекциониста Андрея Агафонова. Больница превратилась в современный по тем временам медицинский центр с 310 койками и передовым оборудованием.
С 1936 года здание официально получило название 2-й городской инфекционной больницы, куда в разное время госпитализировались дети и взрослые с острыми кишечными инфекциями, скарлатиной, тифами, туберкулезными менингитами. Во время Великой отечественной войны из блокадного Ленинграда на лечение прибывали больные с тяжелой дистрофией и кахексией.
Первая в борьбе с пандемией
Сегодня Республиканская клиническая инфекционная больница — это многопрофильное учреждение, оснащенное современным оборудованием и новейшими диагностическими системами.
В 2017 году к больнице был присоединен Городской диагностический центр, что позволило значительно улучшить диагностику инфекционных заболеваний в Татарстане.
Во время пандемии в 2020 году на долю РКИБ выпала главная роль в борьбе с коронавирусом.
Казань стала одним из первых городов страны, где стали оказывать помощь больным COVID-19. Восемь россиян с круизного лайнера Diamond Princess спецбортом МЧС доставили и разместили именно в РКИБ.
Стремительное распространение пандемии потребовало увеличения коечного фонда — за рекордные сто дней в Казани сдали новый корпус больницы. Было закуплено новое, отвечающее новым «пандемийным» запросам оборудование. Но главное – на базе РКИБ были отработаны все процессы сопровождения пациентов с ковидом, внедрены новые методики лечения, ее врачи научились обеспечивать поддержку дыхания тяжелых больных. За время пандемии через клинику прошло более 160 тыс. пациентов с коронавирусом со всего Татарстана.
Сегодня больница способна принять до 700 пациентов, это число предусмотрено на случай тяжелых эпидемий. В обычном режиме здесь развернуты около 500 коек.
Мощности и достижения
На сегодняшний день больница включает в себя несколько отделений, среди которых:
- Реанимационное (в том числе для новорожденных),
- Интенсивной терапии,
- Диагностическое,
- Детское инфекционное,
- Лаборатория для проведения анализов.
В больнице работает более 1,1 тыс. медицинских работников, среди которых 248 врачей и 483 медсестры. Многие из них имеют научные степени и значительный опыт работы с инфекционными болезнями.
Ежегодно РКИБ проводит более 1,4 млн исследований, подтверждая свой статус одного из ведущих медицинских центров не только в Татарстане, но и в России.
Больница активно сотрудничает с Казанским государственным медицинским университетом, что позволяет готовить высококвалифицированные кадры и внедрять передовые методы лечения.
70% от общего числа пациентов РКИБ, как отмечают в клинике, дети и подростки. Лечат тут даже новорожденных. Кстати, именно сотрудники РКИБ первыми взяли на себя заботу о первых детях, которые родились от родителей с ВИЧ-инфекцией.
Республиканская клиническая инфекционная больница имени Андрея Агафонова — это пример успешного сочетания богатой истории, современных технологий и высокой квалификации специалистов, которые ежедневно спасают жизни и противостоят инфекциям.